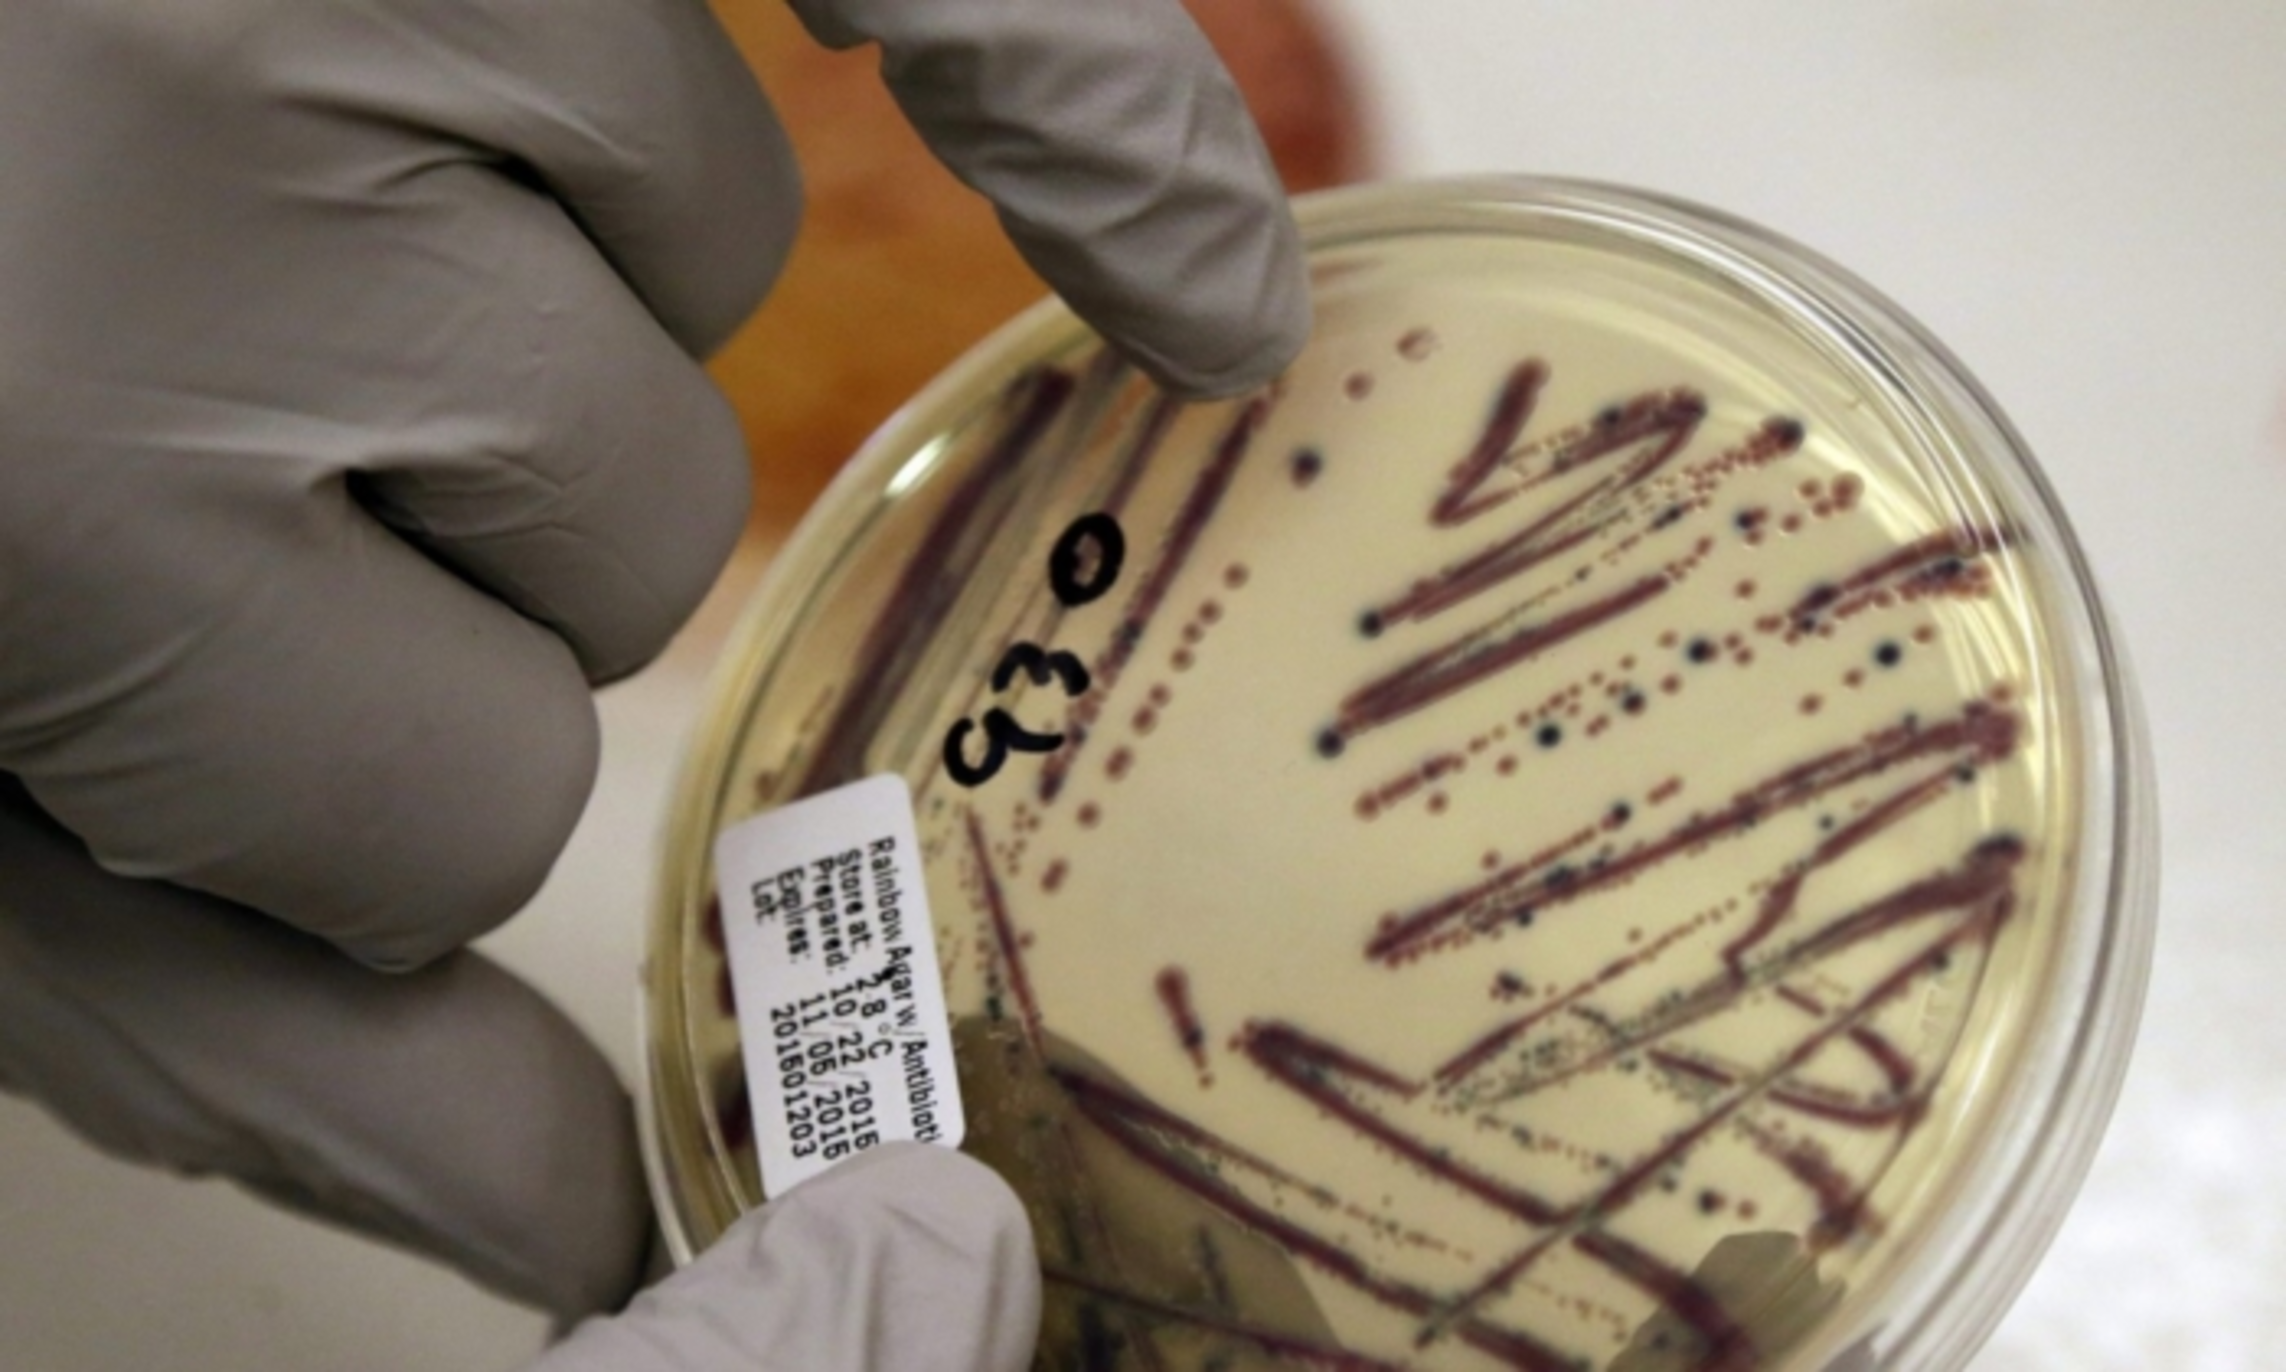

E. Coli Detection Leads to Boil Water Alerts in 2 Mississippi Cities
Published on January 12, 2024
Mississippi health officials issued boil water alerts for the cities of Jackson and Flowood on Jan. 11 after traces of E. coli bacteria were detected during routine water sampling. “Health officials strongly recommend that all water be boiled vigorously for one minute before it is consumed,” the state’s health department said in an advisory. The presence of E. coli indicates that the water may be contaminated with human or animal waste, which generally results from “a problem with the treatment process or pipes which distribute the water,” according to the advisory. “The United States Environmental Protection Agency sets drinking water standards and has determined that the presence of E. coli is a serious health concern,” it stated....
